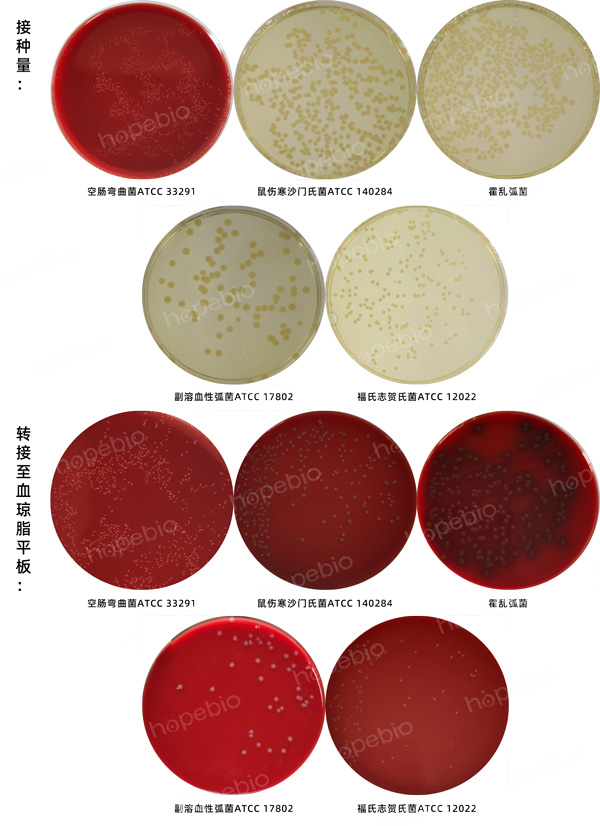

海博微信公众号
海博微信公众号
 海博天猫旗舰店
海博天猫旗舰店


 海博微信公众号
海博微信公众号
 海博天猫旗舰店
海博天猫旗舰店




一、检验原理:
用途:用于运送肠道致病菌。
原理:硫乙醇酸钠抑制氧化而提供还原环境;氯化钠和氯化钙提供重要的离子以维持适合的渗透压;磷酸氢二钠为缓冲剂;琼脂是培养基的凝固剂,少量的琼脂有助于防止因液体对流而迅速产生氧化。
二、培养基配方(g/L):
|
硫乙醇酸钠 |
1.5 |
|
氯化钠 |
5.0 |
|
磷酸氢二钠 |
1.1 |
|
氯化钙 |
0.09 |
|
琼脂 |
5.0 |
|
pH值8.4±0.1(25℃) |
|
三、试验方法:
1、称取本品12.70g,加入1000mL蒸馏水中搅拌加热溶解,分装试管,流动蒸汽灭菌15min,备用。
2、10倍梯度稀释法制备质控菌株菌悬液,吸取适宜梯度的菌悬液(100CFU-1000CFU)接种于无菌拭子和计数培养基胰蛋白胨大豆琼脂(TSA)上,将拭子插入培养基中。
3、放置于20℃-25℃需氧培养48h,拔出拭子,涂抹于血琼脂平板上,观察试验结果。
四、试验结果判断:
接种以下质控菌株,放置于20℃-25℃需氧培养48h。结果如图1。
|
质控菌株 |
菌株编号 |
接种量(CFU) |
生长情况 |
其他特征 |
|
空肠弯曲菌 |
ATCC 33291 |
/ |
+++ |
生长良好(42℃±1℃微需氧培养) |
|
鼠伤寒沙门氏菌 |
ATCC 14028 |
/ |
+++ |
生长良好 |
|
霍乱弧菌 |
/ |
/ |
+++ |
生长良好 |
|
副溶血性弧菌 |
ATCC 17802 |
/ |
+++ |
生长良好 |
|
福氏志贺氏菌 |
ATCC 12022 |
/ |
+++ |
生长良好 |

图1 Cary-Blair氏运送培养基的微生物质控结果
五、注意事项:
培养基中有少量氯化钙,灭菌后的培养基稍浑浊,有少量白色沉淀。
相关产品:
注:本文属海博生物原创,未经允许不得转载。
| 相关文章: | ||



